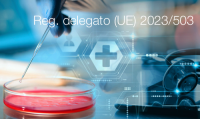

Decreto MIT n. 203 del 1° dicembre 2015
| ID 2210 | | Visite: 7912 | Regolamento impianti fune persone | Permalink: https://www.certifico.com/id/2210 |
Decreto del Ministero delle infrastrutture e dei trasporti 1° dicembre 2015, n. 203
Regolamento recante norme regolamentari in materia di revisioni periodiche, di adeguamenti tecnici e di varianti costruttive per i servizi di pubblico trasporto effettuati con funivie, funicolari, sciovie e slittinovie destinate al trasporto di persone.
(GU n. 296 del 21 dicembre 2015)
________
Art. 1 (Norme tecniche)
1. Sono approvate le "Norme tecniche regolamentari in materia di revisioni periodiche di adeguamenti tecnici di varianti costruttive per i servizi di pubblico trasporto effettuati con funivie, funicolari, sciovie slittinovie destinate al trasporto di persone", di cui all'Allegato tecnico A che costituisce parte integrante del presente decreto.
Art. 2 (Ambito di applicazione
1. Il decreto del Ministro dei trasporti 2 gennaio 1985, pubblicato nella Gazzetta Ufficiale 31 gennaio 1985, n. 26, non si applica, a decorrere dalla data di entrata in vigore del presente decreto agli impianti disciplinati dal presente regolamento.
2. Il presente decreto entra in vigore ii giorno successivo alla sua pubblicazione nella Gazzetta Ufficiale.
...
Collegati
D.D. n. 288 del 17 settembre 2014
Decreto 18 febbraio 2011
Decreto Dirigenziale n. 189 del 29 maggio 2019
La sezione legislazione "Impianti a fune trasporto persone"
Regolamento (UE) 2016/424: Impianti a fune